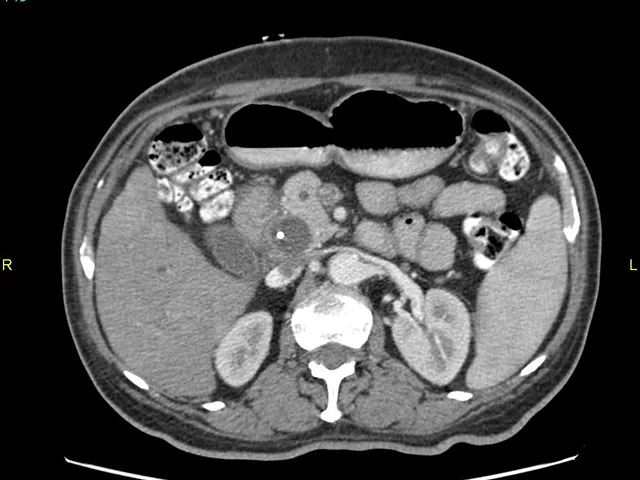

Reporting Course
8 CME Credits
·
Abdominal Radiology, Emergency Radiology
·
Level II
Pancreatitis
The aim of this module is to describe the main imaging findings in acute and chronic pancreatitis.
20 cases
Already have an account?
Description
CT and MR imaging scans will be used for teaching purposes to describe the most typical imaging findings and most frequent complications in acute and chronic pancreatitis.
Learning Objectives
- To describe the main imaging features of oedematous acute pancreatitis
- To describe the main imaging features of necrotic acute pancreatitis
- To describe the main complications of acute pancreatitis
Level
Level II - General radiologist
Technical Requirements
| Hardware | Tablets * | Minimum | Recommended |
|---|---|---|---|
| Memory (RAM): | 2 Gigabyte | 8 Gigabyte | 16 Gigabyte |
| Processor (CPU): | Dual core 1.85 Ghz | Dual core 2 Ghz | Quad core 2.5 Ghz |
| Internet connection | Minimum | Recommended | |
| Speed: | 10 Mbps | 25 Mbps | |
| Software | Tablets | Desktop | |
| Browser: | Safari * | Chrome ** | |
- * Tested with Safari on iPad 9.7 (2017), should also work on Android with Chrome. User interface not optimized for smaller screens. Large cases (more than 600 images) are not able to be opened on tablet or mobile devices due to memory consTableRowaints.
- ** Firefox, Edge and Safari also work but might not provide an equally smooth experience. Internet Explorer is not supported.
Introduction Video
Lecturers

Emilio Quaia M.D.
Italy, Padova
Full Profesor of Radiology, University of Padova (Italy)
Emilio currently holds a Full Profesor of Radiology position at the University of Padova in Italy. He completed his Medical Training at University of Udine (Italy) with an MD thesis on pharmacology in 1995. Afterwards he completed his radiological training at University of Trieste (Italy) in 1999.
Dr. Quaia has worked in Hammersmith Hospital in London for one year. In 2000 he became assistant professor in radiology at University of Trieste. In 2005 he invested one year in MSKCC in New York with the role of Research Associate in Molecular Imaging. After this year in the US he decided to came back to Trieste, where in 2014 he was appointed as associate professor in radiology, position which he covered until October 2016. Then he moved to the University of Edinburgh where Emilio remained for 2 years as Honorary Consultant in Radiology until august 2018 when he finally became Full Professor of Radiology at University of Padova (Italy) position which he is presently holding.
His principal field of clinical activity and research is Abdominal Imaging with particular dedication to US, contrast-enhanced US, CT and MR imaging.




